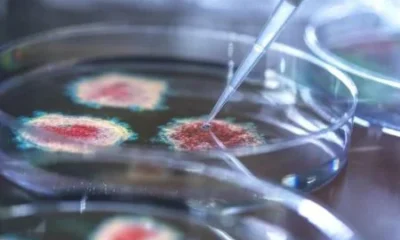
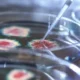

Há pouco mais de um mês, o Ministério da Saúde anunciou a incorporação da vacina contra a dengue no Sistema Único de Saúde (SUS). Antes disso,...
Foto: Reprodução Vacinação contra HPV está em queda A vacinação contra o HPV é fundamental na defesa da saúde, não apenas das mulheres, mas também dos...
A primeira remessa da vacina contra a dengue que será oferecida pelo Sistema Único de Saúde (SUS) chegou ao Brasil neste sábado (20). O governo recebeu...
Uma investigação da Controladoria-Geral da União (CGU) concluiu que é falso o registro de imunização contra a covid-19 que consta do cartão de vacinação do ex-presidente...


Foto: Ascom Prefeitura de Arapongas Só na capital paulista, a Secretaria Municipal da Saúde estima que 130 mil mulheres possam receber a dose a partir da...

Especialista esclarece as principais dúvidas sobre o vírus responsável pelo câncer do colo do útero. Saiba como se proteger Alto Astral TEK IMAGE/SCIENCE PHOTO LIBRARY O...


Imunizante só está disponível na rede de saúde privada. Homens e mulheres entre 9 e 45 anos podem tomar a vacina Yasmin Gurgel Getty Images As...